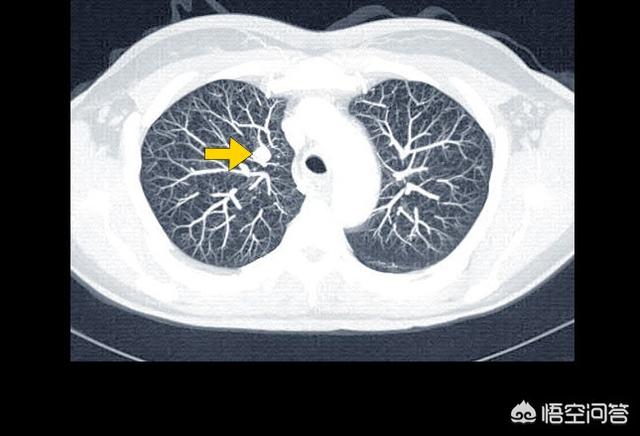

肺がん患者は通常どのように亡くなるのか?
肺がん患者は通常どのように亡くなるのか?
このテーマはかなり重いが、多くの肺がん患者とその家族が直面しなければならないことである。肺がんの罹患率、死亡率は悪性腫瘍の中で第1位であり、治療法も比較的多くなってきているが、その効果は決して楽観できるものではない。すべての治療が効果的でなく、患者の体調が徐々に悪化すると、生命を脅かすさまざまな事態が発生する。肺がんに限らず、実際、すべてのがん患者は、最終的にはがんそのものではなく、多臓器不全で死亡する。

肺がん患者の死亡は、以下のような原因によって引き起こされる可能性がある。
1.呼吸不全は、一般に患者の空気不足として知られ、進行肺癌患者に最も多い。中枢性肺癌では気管や主気管支が閉塞して空気が入りにくくなり、肺の無気肺が大きくなると、次第に息切れや呼吸困難に悩まされるようになる。胸膜転移により大量の胸水が貯留し、肺組織が圧迫されて肺が再開通できなくなる患者もいる。また、肺病変が多すぎて有効呼吸膜面積が著しく減少している患者もいる。これらの理由はすべて、最終的に胸部圧迫感、息切れ、座位呼吸を引き起こし、最終的には呼吸不全に至る。

2.重篤な感染症 肺感染症は肺癌患者に非常に多い合併症であり、死因でもある。肺病変や気道閉塞が存在するため、進行期の肺癌患者では痰や細菌が排出されにくく、あらゆる細菌や真菌の感染が起こりやすい。 免疫機能が極端に低下しているため、一流の抗生物質を使用しても肺感染症をコントロールすることは難しく、敗血症や感染性ショックを起こし、生命が危険にさらされる。

3.極度のやせ:腫瘍そのものが体の栄養とエネルギーを奪う一種の病気であり、進行した肺がん患者は食欲不振、吐き気と嘔吐、栄養摂取不足、腫瘍細胞の消費にも常に悩まされることになり、最終的には全身の臓器に栄養が供給されなくなる、いわゆる「悪性体液うっ滞」に陥りやすく、実際に多臓器不全で死亡する。最終的に患者は多臓器不全で死亡する。

4.喀血と窒息 肺癌患者の多くは痰に血が混じる症状があり、特に中枢性肺癌の場合、腫瘍が太い血管に浸潤すると喀血が起こり、血液が気道に流れ込んで窒息し、生命が危険にさらされることがある。

5.痙攣性昏睡 肺癌脳転移の病変が徐々に大きくなると、脳水腫、頭蓋内圧亢進、あるいは脳ヘルニアが現れ、患者は激しい頭痛と嘔吐に襲われ、重要な部分の転移病変が二次てんかんを誘発し、患者は痙攣して昏睡状態に陥り、患者の生命が危険にさらされる。

6.電解質障害 肺がん患者の30%は、がん症候群、異所性ホルモンの分泌、低ナトリウム、低カリウムなどの頑固な電解質障害を合併している。

7.血栓症:進行した肺癌患者の血液は凝固が高い状態にあり、血栓症になりやすく、血栓や癌塞栓が重要な臓器に脱落すると、心筋梗塞、脳梗塞、肺塞栓症などを引き起こし、臨床的にも化学療法を受けた患者が突然心筋梗塞で死亡するケースに遭遇している。

8.転移巣が臓器不全を引き起こす 肺がんは肝臓、腹腔、腎臓に転移することがあり、転移巣が多くて大きいと、圧迫や閉塞の症状が出るだけでなく、肝臓や腎臓の機能にも影響を及ぼし、肝不全や腎不全を引き起こし、腹腔内に広範囲に転移があると腸閉塞を引き起こし、食事がとれなくなり、過労死する。

9.治療関連死 肺癌の治療関連死は稀ではない。 化学療法、放射線療法、分子標的治療、免疫療法などの肺癌の治療法には、いずれも相応の毒性副作用があり、治療過程で様々な毒性に耐えられず死亡する患者はごく少数である。

ビッグデータは素晴らしいと言わざるを得ない!
数時間前、蘇生室で働きながら末期の肺がん患者の死に立ち会ったばかりだったので、帰宅してこの質問を受けるのに時間はかからなかった。
もし偶然の一致がなければ、もし私がこのようなトピックを頻繁に追っていなければ、私は本当に尾行され、監視されているのではないかと思っただろう!
こういうことだ:
数時間前、81歳の高齢男性患者が蘇生室に収容された。
患者の容態は極めて重篤で、重度の呼吸不全と多臓器不全に陥っていた。実際、この患者は進行した肺がん患者だった。
どのような病気であっても、死を前にしたとき、医師は必ず家族に、採りうる手段とその長所と短所を伝え、家族が選択できるようにしなければならない。
このような患者を前にして、まず取り組むべきは、当然、酸素化を改善し、低酸素症の問題を解決することである。そうでなければ、すべての蘇生が無駄になる。
しかし、息苦しそうにしている患者のベッドサイドで、患者の子供たちは断固として、気管挿管の提案を一様に拒否した。
子供たちの決断はよく理解できる。実際、ある意味、この世を早く去ることは、患者にとって救いでもある。
「挿管なし、人工呼吸器なしは死を意味する。
"OK!"
こうして、患者は最後の2時間を蘇生室で過ごし、子供たちや医師たちの前でゆっくりと息を引き取った。
実際、肺感染症の再発、重度の胸水貯留、大量の喀痰閉塞、呼吸不全の持続は、肺がん患者のほとんどが最終的に直面する試練そのものである。
もちろん、電解質異常、ショック、多臓器不全など、肺がん患者の死につながる原因はたくさんある。
ドーパミンのように生死の境をさまよう蘇生室に慣れ親しんだ医師でさえ、必死に呼吸する姿を見ていると、まるでネギが卵の黄身をかき混ぜたような一般的な粘り気のある痰を吐き出すことができず、またいくつかの悲しい感情を避けることができない。
医者としてできることはほとんどないからだ!
一般人である以上、誰もこの最終的な結論から逃れることはできないからだ!
より多くの人に少しずつ知ってもらう!
最後のドーパミンは、救急医、多くの人との出会い、多くのものとの出会いだった!
これはいささか悲観的な質問ではあるが、医師たちを駆り立てるものでもある!技術は急速に進歩しているが、腫瘍治療の進歩はそれ以上ではない!肺がんは依然として死亡率が最も高い悪性腫瘍である。
国立がんセンターが発表したデータによると、2015年、中国でのがん死亡者数は約233万8000人で、そのうちの1割が死亡している。肺がんによる死亡者数は631,000人で、これは人口10万人のうちおよそ45.8人が肺がんで死亡することを意味する。肺がんの予防と制御は、がんとの闘いの重要な部分である。
肺がん患者は通常どのように亡くなるのか?
1.最も多いのは呼吸不全
人間は、肺の空気交換機能に頼って酸素呼吸を行い、地球上で生存している。肺不全は、巨大な腫瘍、大量の胸水、広範な肺転移、気道閉塞などの進行した肺がんによって引き起こされることが多い。

この患者はまだ39歳で、胸のつかえと息切れがあり、右肺の腺がんと診断され、多量の胸水が貯留し、右肺全体の機能が失われていた。このような重篤な状態は高齢者にやや多く、放置すればすぐに呼吸不全に陥る。幸いなことに、彼女は標的治療に感受性があり、胸水をコントロールしながら3年以上腫瘍と共存している。
2.二次感染
肺がん患者は免疫力が低下しているため、気道が狭くなり、通常、閉塞性肺炎を引き起こし、時には命にかかわることもある。
これは79歳の男性で、4年前から小細胞肺がんを患っている。右下葉の気管支が狭くなっているため、閉塞性肺炎を引き起こし、高熱を繰り返す。
3.重要臓器への転移
がん細胞は恐ろしいもので、脳転移や肝転移など、血管やリンパのあるところならどこにでも転移する。
このような巨大な肝転移が多発した場合、コントロールできなかったり、治療に反応しなかったりすると、短期間で進行する可能性がある。
4.患者はがんを悲観し、過度に恐れ、治療をあきらめる。
時には、自分が癌に侵されていることを知ってから、意気消沈し、飲まず食わずで、家族にもキレて、治療にも協力せず、食事も睡眠もろくにとらず、やがて身体もダメになってしまう......というような患者に出会うこともある。
癌の末期はより辛いものであり、人道的に扱われるべきである。患者の快適性を高めることを第一義とする過剰治療を推奨しているわけではない。
画像診断のドクター・ハウです!
肺がんでは、いろいろなことが起こる。
入院しなければ、電解質異常、悪性不整脈による死亡、胸部圧迫感が一度に起こり、その後急速に死亡することが多い。
入院していれば、このような電解質異常は簡単に解消されるし、採血して血液が少ないとわかれば、あとは戻すだけだ。
病院でよく見られる死亡例には以下のようなものがある:
まず呼吸不全。終末期を迎える頃には、その患者は両肺の機能が低下し、最終的には呼吸不全で死亡する。このような患者は、溺死した人たちのように、最も苦しく、持続的な呼吸困難があり、常に早く溺れているような状態である。
第二に、喀血は窒息死につながるが、これもわかりやすい。喀血が突然起こると、呼吸が妨げられて救えなくなり、あっという間に死に至るからだ。
第三に、脳転移が起こり、中枢系に問題が生じて死に至る。
第四に、死亡に至った他の地方移籍があった。
第5に、呼吸困難が増大し、最終的には呼吸不全で死に至る重篤な感染症である。
第6に、全身不全による死亡である。
私は物事を計画することが好きなので、健康についてもっと知りたい方は、ぜひフォローしてください。
がんによる死について語ることは、多くの患者やその家族にとって直視したくない話題だが、同時に残酷で現実的な問題でもある。数カ月でがんで亡くなった人、治療がうまくいっていたのに突然亡くなった人などの話をよく耳にする。このような話題は、人々をがんに対してより不機嫌にさせ、がん患者の正常な治療につながらない。
WHOのデータによると、肺がんは年間罹患数、年間死亡数ともに世界第1位で、罹患率はますます高くなっている。
肺がんの死因は何ですか?
1.臓器不全
進行した肺がんの多くは、肝臓、脳、骨に転移し、臓器不全に至ることがある。
2.肺感染症
一方では、進行した肺癌患者は、腫瘍が気管を圧迫し管腔を閉塞するため、痰をスムーズに排出できないことがある。他方、進行肺癌患者は消費量が増加し、食欲が低下するため、栄養不良や免疫力の低下を招く可能性がある。これらはいずれも肺内感染を引き起こしやすい。

3.多量の吐血
肺がん患者が激しく咳き込むと、腫瘍と小動脈の癒着が破れて気管支が破裂し、大量の血液を吐き出して気道をふさぎ、窒息死に至ることがある。
4.胸水
胸水貯留は肺癌患者によくみられるもう一つの合併症であり、胸水が大量に貯留すると呼吸困難に陥ることがある。
5.肺塞栓症
肺がんや消化器腫瘍などのがんは、主に血液が凝固亢進状態にあるために肺塞栓症を起こしやすく、化学療法薬や化学療法の過程もその一因となる。
私の答えがあなたのお役に立てれば幸いです!もし気に入っていただけたら、「いいね!」をお願いします!

私の叔母は、3月15日に肺がんのため、永遠に私たちのもとを去った。
痛みに耐えかねて病院へ行き、末期の肺がんだとわかったことをはっきりと覚えている。その時、私の妹はまだ大学に通っていて、たまたま家にいたので、叔父は妹が大学に行くのを待ってから叔母にそのことを告げた。私も叔母に、叔父はずっと痛がっていたのだから、腎臓結石ではないはずだ(叔母は腎臓結石だったのだから)と言い、病院で検査を受けるように言ったのを覚えている。実際、その時すでに襄陽第二別館にいたのだが、叔母から知らせがあった。叔母は背が高く、いつも健康で、普段から健康に気を配り、年に一度は健康診断を受けていた。今思えば、悪いのはタバコだけだった。
At the beginning of the time there are targeted drugs can eat, and still from the cheapest kind of eat, then still and normal people, outsiders can not see that he is sick.彼の病気のために、私の妹は看護を勉強していた学士号を準備するために学校にいた、最終的にインターンシップに戻ってきて、自分たちの努力によって鎮の保健センターに入って、安定した仕事があります。姉の夫は同級生で、姉にとてもよくしてくれた。姉は20年9月に正式に就職し、11月に結婚した。結婚した妹の家族を父に見せたかったからだ。
実際、姉が結婚する前、叔父の体調はあまり良くなかった。 結婚式の日、叔父は外に出てこず、自分の部屋で寝ていた。姉は午前中に出かけ、叔父は午後に病院に入った。体に免疫がなく、風邪をひいていて、あまりよくなかったからだ。翌日、私は薄いご飯を炊いて病院に行った。その時、叔父は顔の半分も動かせず、乾いたものも食べられず、スープと薄いご飯しか食べられなかったからだ。私にまで話しかけてきて、大盛りのご飯を食べていた。体調が悪くなるにつれ、病院に見舞いに来る人を嫌がるようになったので、私はめったに病院には行かなかった。その後、私たちの側の病院が新病院に移転することになり、新病院には個室がなかったため、彼は家に帰りたがらなかった。
死期が迫ったとき、すでにガリガリに痩せ細り、体には肉もついておらず、最期は水しか飲めず、スプーン1杯の水を2回に分けて飲ませ、プロテインパウダーと粉ミルクもスプーン1杯を水っぽい飲み物に調整するしかなかった。注射針も刺せず、血圧も測れないと叔母から聞かされ、その夜、叔母と二人で見守り、まだしゃべることができたので、足を押したり、足を引っ張ったりしてもらうと、昼間よりずっと足が冷たく、足を押したり、足を引っ張ったりし続け、すでに命が危うく、寝心地も悪かった。以前は鎮痛剤を2錠飲ませれば数時間は眠れたが、その頃は2日2晩眠れず、モルヒネも効かなかった。また、余命いくばくもないとわかっていたので、叔母に姉と義兄を呼び戻すよう頼んでいた。亡くなる日、彼の精神状態は明らかに違っていました。いつもは寝返りを打っても、まだ少しは努力し、はっきりと自分の気持ちを表現することができたのですが、その日は寝返りを打っても、全く努力することができませんでした。寝返りを打った後も、彼は私たちに手を当ててほしいと言い、私たちが手を当てなければ、すぐに倒れてしまいました。足はさらに冷たくなっていて、私たちに足を引っ張ったり、足を押さえたりしてほしいとは言いませんでした。最後の日、彼は次々と苦しそうに叫び、自分の胸を指差し、決してそんなに叫んだことはありませんでした。叫び続けました。最後の日、胸を指差して痛そうに叫んだ。あんなに叫んだことはなかった。叫び続けた。水も飲めず、喉には痰がからみ始めた。妹は病院で処方されたダルコラックスを半分しか飲まなかった。そして叔父はどこかへ行ってしまった。
父は私が2歳のときに病気で出て行ったので、私の印象では、叔父は父の半分のような存在で、思い入れがあります。叔父は50歳足らずで出て行ったので、まだ孫にも会えず、そのままどこかへ行ってしまったのですが、今でも夢のようで、とても非現実的です。叔父があの世で病気で苦しむことなく、以前のように優雅に過ごしていることを願っている。
私の母は肺がんを患い、昨年4月1日に亡くなりました。発覚から亡くなるまで5年近くかかったので、その過程はとても印象的でした。
生検、化学療法、標的薬の服用(耐性が強いため、薬を何度も切り替えなければならなかった!1日2錠、最後の3錠、4錠は効きませんでした)。免疫療法や放射線療法も試したが効果がなかった。
最後の1年はもっと苦しく、眠れないほどの痛みがある。
亡くなる3ヶ月前、母は旧正月の29日に市立病院から県立病院に転院した。私たち三姉妹は順番に待つために、私の母はまだ病棟からナースステーションに人々のサポートの中で手すりを抱えて松葉杖をつくことができる15日の最初の月に付着し、ちょうど食べたくない、特に油で塩辛い食べないで、毎日卵と麺を飲むことです水の大きなボウルを飲むことができ、最初はまた、ガスを遅くするために目を閉じて停止するために食べるために2つの口の半分から4分の1を購入するために饅頭の種類を食べた非常に疲れて、非常に疲れて、外観は、目を開けたくなかった。ボーッと一日中。特に日中は、輸液が混乱し、眠りたいでしょう。
午後10時以降、ほぼ1時間おきに目を覚ますと、まったく熟睡できない。毎晩寝る前に看護師を呼んでモルヒネを注射してもらうのだが、その注射が終わるとまた痛みが始まるのだ。しかし、この注射は1日に多くても6回までで、命にかかわることはない!
奇妙なことに、最後の私の母は、特に明確に覚えているために注射に、混乱している何を言うために、 "注射をする時間ではありませんか?"と叫ぶためにしばらくの間混乱している。私は言った: "時間未満 "彼女はその後、5分未満を混乱させ、繰り返し私に尋ねた、私は再び言わなければならないように、彼女は呪うようになった "私は痛みに苦しんでいる、叫ぶために急いで "と言った私は、彼女は針を再生するために1時間前だけであることを知っている、私はちょうどに看護師に行ったことをなだめる上で再生する勇気はありません。看護師は他の人に注射をしていて、しばらくして戻ってくるとのことだった。彼女はニヤリとしばらく眠った後、私は痛みを和らげるために彼女の全身マッサージを与えるために急いでいた、そしてゆっくりと背中優しく愛撫愛撫、彼女をひっくり返して、またはスリープ状態に長い時間、彼女はもっと痛くなります。そうすることで、彼女は次の注射まで、なだめすかしたり、話しかけたりしながら、もう少しの間持ちこたえることができるのだ。
今になって、なぜママがいつも口が乾いていると言っていたのかがわかった。おそらく、最後は肺が働かず、口でしか呼吸ができなかったから、口が乾いていると一日中泣いていたのだろう。私たちは彼女が飲みやすいように、ティーカップにストローをさしただけだ。
ある夜11時頃かもしれない、彼女は、心臓が不安をキャッチするために、呼吸することはできませんが、不安な手が足をかき混ぜるかき混ぜる、顔の筋肉がコマンドに耳を傾けない、速効性の心臓の薬を食べても動作しないと述べた!慌てて当番医のドアをノックして、当番医は私がまず当直看護師を呼びに行って、彼の即時の上昇のために準備させ、私は当直看護師を呼びに急いで、当直看護師はドアに来てハァハァして、私はしばらく待ってみましょう。私は不安でまっすぐ足を踏み鳴らし、当直看護師は蹴り、ゆっくりと靴を引っ張り出し、彼女の外を見て、私は病棟に戻ってすべての道を走ったが、母の痛々しい姿を見て、私は不安でしたが、何をすべきかわからない?私はただ、お母さん、お母さんは、医師がすぐにここに来るので、ちょっと待ってください......と叫ぶしかなかった。
約2分ほどして、看護師がやっと来て、酸素マスクをベッドサイドに挿入し、私は急いで酸素マスクの上に母に手と足。「看護師、私の母の心臓は非常に緊急事態をキャッチするために、これだけはああすることはできません...... "私は急いで看護師に行く準備を停止するために叫んだ。"その後、薬を処方する医師を見つける "彼女は無表情の文章を返すと去りました。先生、先生はどこですか?私は廊下に向かって叫んだ。廊下の反対側で足音が聞こえた。医師は慌てず母を見回すと、聴診器を取り出し、母の心臓に当てて聴診し、包み込むように言った。「どうしましょう?「お薬のリストを取ってきてください」と医師は診察室に入った。私は、まず付き添いの臨床医に母を見てもらうしかない。
しかし、結局のところ、非常に効果的な薬ですが、一瞬しか管理できず、その後投与量を増やしても効果がありません。私の母は亡くなるまで、また1ヵ月も持ちませんでした......。
喫煙者の多さと大気汚染のため、肺がんは中国で最も罹患率の高いがんで、毎年80万人以上の肺がん患者が新たに発生しており、2位の胃がんの2倍である。一方、死亡者数も肺がんが最も多く、毎年60万人以上の患者が肺がんで亡くなっており、他の腫瘍よりもはるかに多い。肺がんはすでにわが国のがんの第1位といっても過言ではない。
早期肺癌の治療効果は良好で、治癒率は90%以上であるが、進行期肺癌の生存率は著しく低下し、死亡率も高い。肺癌患者は通常、以下のような症状で死亡する:
(1) 呼吸不全で死亡
私たちが呼吸するには両方の肺が必要で、肺が腫瘍でいっぱいになると、呼吸する能力を失い、がんが気道をふさぐこともあり、胸水もたまり、その多量が肺を圧迫して呼吸困難を引き起こす。肺が働けなくなれば、やがて酸素が不足し、全身の臓器が血液と酸素を奪われ、ついには死んでしまう。

(2) 喀血
また、肺がんが血管を侵し、強く咳をした後に血管が破裂して出血し、気道を塞いで窒息死したり、出血性ショックを起こしたりすることもよくある理由です。当院でも肺癌の進行期の医師が喀血し、病院全体で積極的な蘇生を行っても助からなかったことがあり、非常に残念でした。

(3) 腫瘍転移
進行した肺がんは、体内のさまざまな臓器に多発転移を起こすことがある。 肺がんは脳、肝臓、骨格椎体系に転移することが多く、脳転移は頭蓋内圧亢進症を引き起こすことがある。 脳のスペースが限られているため、がん細胞が増殖すると脳ヘルニアや頭蓋内圧亢進症を引き起こし、生命を脅かすことになる。椎体転移は、病的骨折や神経の圧迫を引き起こし、麻痺や死に至ることもある。多発性肝転移は、肝機能障害や肝不全を引き起こす可能性があります。

(4) 腫瘍悪性、多臓器不全
腫瘍患者の多くは、最終的に栄養失調と多臓器不全で死亡する。これは、がん細胞が大量に増殖し、腫瘍細胞が狂ったように増え続け、体内の栄養素を奪い、栄養失調、体重減少、悪性疾患を引き起こし、すべての臓器の機能が影響を受けるからである。

(5) 副作用の治療
放射線療法であれ、化学療法であれ、手術療法であれ、標的療法であれ、何らかの副作用が出る可能性がある。ただでさえ体力が落ちている末期がんの患者さんは、治療の副作用と相まって、白血球減少、顆粒球減少、重度の貧血、血小板減少など、より深刻な問題を引き起こす可能性があり、感染症と組み合わさると生命に関わることもあります。したがって、末期がん患者は症状を和らげることに重点を置き、強すぎる治療薬を使用すべきではない。
結局のところ、肺がんの治癒率を上げるためには、早期発見と早期治療が必要なのである。
がん患者の死となると、どちらかというと重苦しいムードが漂う。実際、ステージの異なる癌患者の転帰は異なり、肺癌も同様である。肺がんは中国における主要な悪性腫瘍の一つであり、その罹患率と死亡率は年々増加しているが、早期肺がんの5年生存率は外科治療後100%に達することができ、これは早期肺がん患者の大部分が治癒できることを意味する。II期肺がんの5年生存率は60%~70%、III期肺がんの5年生存率は50%前後、IV期肺がんの5年生存率は10%~20%前後と非常に低い。もちろん、化学療法、放射線療法、分子標的治療などの介入が行われていることが前提条件である。

肺がん患者は通常どのように亡くなるのか?
1.呼吸不全:周知のように、肺は呼吸器の主要な臓器であり、肺がん患者、特に進行期の肺がん患者は、がん細胞が正常な肺組織を破壊するため、呼吸困難に陥ります。がん細胞が脳転移、肝転移、骨転移など全身に広がれば、全身の体内環境が乱れ、呼吸不全の原因にもなる。進行した肺がん患者の大半は、呼吸不全に陥った時点で末期を迎えている可能性があり、家族は心理的な準備をする必要がある。
2.極端な浪費:衰弱は進行肺がんの主な症状であり、主に腫瘍の消費と食事に関係している。一方では、腫瘍が成長し続け、より多くの栄養素を消費する。つまり、癌細胞は人体の正常な組織や細胞と栄養素を奪い合うため、栄養素は人体の正常な需要を満たすには不十分となる。他方では、肺癌は患者の食欲不振、吐き気や嘔吐、呼吸不良を引き起こし、これらはすべて衰弱の原因となる。人体が極度に衰弱すると、全身の臓器に栄養が供給されなくなり、やがて臓器不全を引き起こす。
3.窒息またはショックを引き起こす喀血:腫瘍がガスの通り道を塞ぎ、気管支壁を刺激し、気管が異物を排出しようとするため、咳が生じ、時に痰に血が混じる喀血となる。腫瘍が太い血管に浸潤すると、血管が破裂して喀血することがあり、劇症に血流が流れ込むと窒息やショック状態に陥り、生命を脅かす。一般に、患者が喀血症状を呈した場合は、病気が進行していることを意味する。

4.腫瘍転移、多臓器不全:肺癌の末期には様々な臓器への転移が起こり、患者に大きな苦痛を与える。肺癌患者は胸膜、脳、副腎、肝臓、骨、心膜などの臓器に転移し、多臓器不全を引き起こし、患者の死に至ることもある。
5.重い感染症一部の肺癌患者の死亡診断書には、死因が「肺感染症」、つまり肺癌による肺感染症と書かれている。肺感染症は間違いなく無視できない危険因子である。肺癌患者の68.18パーセントが直接または間接的に肺感染症で死亡したことが研究で示されており、肺感染症を有する進行肺癌患者の死亡率は27.96パーセントであったという研究もある。
そのほかにも、電解質異常、けいれん性昏睡、血栓症など、肺がん患者の死に至る原因はたくさんある。肺がんの末期になると、患者とその家族は、治療を続けるか、治療を断念するかという選択を迫られることになる。治療を続けるには、莫大な費用がかかり、結果は二の舞になる可能性が高く、患者は庶民には耐え難い苦痛に耐えなければならない。治療を断念するにも、苦痛に耐えられず、病院のベッドに横たわる愛する人を見ながら、何もできない。結局、どのような選択をすべきなのか。実は、考慮すべき要素はたくさんある。第一に医師のアドバイスに耳を傾けること、第二に患者の選択を尊重すること、さらに家族の経済状況を考慮することである。
私は黄志燕医師です。複雑な病気の知識を平易な言葉で説明し、皆様の身体管理のお役に立てるよう努力しています。皆様からのお褒めの言葉が、私の最大のモチベーションです!また、肺がんで苦しんでいるご家族がいらっしゃいましたら、ぜひこの記事をお伝えください!
新関流行の際、私は発熱外来をサポートするため救急部に配属されたが、ある日、当直中に肺がん再発の患者が発熱し、問診したところ、その患者は私の高校の同級生の父親で、不幸にもその父親も肺がんを発症していた。
最近、私の周りでも肺がんに罹患する人が増え、見つかったときには転移があり、すぐに亡くなってしまう人が多いと感じる。 ここでは、肺がん患者の終末期の生活状況について簡単に紹介したい。
調査によると、2012年には世界中で約180万人の肺がん患者が新たに発生し、160万人が死亡したと推定されている。
喫煙は肺がんの主要な危険因子であり、肺がん全体の約90%を占めると推定されている。1日1箱のタバコを40年間吸い続け、禁煙していない人の肺がん発症リスクは、非喫煙者の約20倍である。


進行した肺がんの主な症状は?
- 腫瘤が肺を圧迫して無気肺を引き起こすため、呼吸が困難になる。腫瘍が気管や気管支を圧迫し、肺の一部が閉塞する。
- 肺癌が胸腔に転移すると、胸水、特に血性胸水が貯留することがあり、この時に血を吐くことがある。
- 腫瘍は発熱を伴うこともある。
- 痰を吐く。
- 骨転移がある場合は骨の痛みもある。
- 胸膜痛。
- 衰えと弱さ。
- また、腫瘍は体を凝固亢進状態にするため、血栓ができやすく、血栓が外れて肺塞栓症になりやすい。
- 待ってくれ......。

腫瘍は人体のエネルギーを少しずつ消費し、やがて悪性の病気が現れる。 人々は特に衰弱し、やせ細り、何もする力がなくなる。さらに、肺がんは局所的に呼吸困難を引き起こし、非常に深刻である。 人体がある程度消費されると、呼吸はますます衰弱し、最後には呼吸不全が現れ、呼吸停止や心停止が起こり、死に至る可能性が非常に高い。
肺がんを予防するために何をすべきか?
- 禁煙、1日1箱の喫煙を40年間続けている人で禁煙していない人は、非喫煙者の約20倍の肺がん発症リスクがある。
- 副流煙、一部のアスベスト、特定の金属(ヒ素、クロム、ニッケル)、電離放射線など、がんを引き起こす可能性のある環境的危険因子を避けるようにする。
- 少喝酒。
- 間質性肺線維症の患者は速やかに治療する。
- バランスの取れた食事、栄養強化、赤身肉の摂取量をやや減らし、白身肉の摂取量を適切に増やす、新鮮な野菜や果物、抗酸化物質、アブラナ科の野菜を多く食べる。
- 免疫力を強化するために運動量を増やす。
- 道路を走る長距離走はなるべく避けるなど、環境汚染地域での有酸素運動は避けるようにする。これは、車の排気ガスを吸い込みすぎて肺疾患のリスクが高まるのを防ぐためである。
- 気分の低下や抑うつ状態は免疫力にも影響を及ぼし、腫瘍の発生リスクを高める可能性があるため、気分を調整できるようになることが重要である。

医療についてもっと知るために、医療をもっと簡単にフォローする。
この質問と回答はサイト利用者のものであり、サイトの立場を代表するものではありません、侵害など、削除するには管理者に連絡してください。